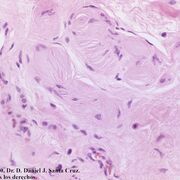
APE_Anita

Learn Anatomia Patologica
Study Anatomia Patologica using smart web & mobile flashcards created by top students, teachers, and professors. Prep for a quiz or learn for fun!
Brainscape Certified Flashcards (0)
Decks
Flashcards
Learners
User-Generated Flashcards (185)
Decks
Flashcards
Learners
-
Anatomia Patologica I
Anatomia Patologica I
By: Roberto Felix
Clase 1 y 2, Clase 1 incompleta, Clase 3...6Decks168Flashcards1Learner -
Anatomía Patológica AYÚDANOS DIOS
Anatomía Patológica AYÚDANOS DIOS
By: Krisbel Mejias
Pene, Escroto, Testículo y Epidídimo, Neoplasias Testiculares...5Decks193Flashcards1Learner -
APE_Anita
APE_Anita
By: Eva soriano
Examen Teoría Junio 20-21, Examen Seminarios Junio 20-212Decks80Flashcards2Learners -
Terceiro Período

Terceiro Período
By: Carmem Fernanda Prado Lima
Sepse, TUTORIA P4 - ARTRITE GOTOSA, Corticoesteroides...18Decks72Flashcards2Learners -
Anatomía Patológica II
Anatomía Patológica II
By: Paola Rios
Enfermedad Inflamatoria Intestinal, Pancreas y Vias Biliares, Patologia Del Intestino Delgado Y Colon...4Decks80Flashcards1Learner -
Anatomia Patológica
Anatomia Patológica
By: Ana Luisa
Vasculitis, Tumores Vasculares, Neoplasias3Decks52Flashcards1Learner -
Anatomia patológica especial
Anatomia patológica especial
By: Giuliano Tassara Mejia
Tema 1: Malformaciones cardiacas y de grandes vasos, Tema 2: Patologia inflamatoria del corazon, Tema 3: Miocardiopatias...6Decks130Flashcards1Learner -
Anatomia Patológica
Anatomia Patológica
By: Joicy M. N
Técnicas Histológicas, Inflamación y Reparación2Decks19Flashcards3Learners -
Anatomía Patológica
Anatomía Patológica
By: Natalia Pérez González
Dermatopatología, Cardiopatología y hemodinamia2Decks66Flashcards1Learner -
ANATOMIA PATOLOGICA UROLOGIA
ANATOMIA PATOLOGICA UROLOGIA
By: Sofia Nughes
TUMORE TESTICOLO, tumori a cellule germinali, seminoma...13Decks122Flashcards1Learner -
Anatomía Patológica
Anatomía Patológica
By: Mayerli González
Cáncer de colon, Pólipos neoplásicos, Pólipos NO neoplásicos...4Decks87Flashcards1Learner -
Simulacros/test
Simulacros/test
By: Eduard Cadavid
Anatomia, Anatomia Patologica, Anestesiologia...38Decks125Flashcards2Learners -
Anatomía Patológica
Anatomía Patológica
By: Laura Guzmán
Carcinoma de mama1Decks38Flashcards2Learners -
Anatomía Patológica
Anatomía Patológica
By: Carmen Manzano Ramos
Reacciones Hipersensibilidad, Enfermedades Infecciosas, Inflamacion Crónica...7Decks82Flashcards1Learner -
APE (Anatomía Patológica Especial)

APE (Anatomía Patológica Especial)
By: Eva soriano
Examen Teoría Junio 20-21, Examen Seminarios Junio 20-212Decks80Flashcards1Learner -
Anatomia Patológica

Anatomia Patológica
By: Leticia Luísa
Sistema Circulatório, Sistema Respiratório2Decks92Flashcards1Learner -
ANATOMÍA PATOLÓGICA
ANATOMÍA PATOLÓGICA
By: Fernanda Maroto
Lesión, inflamación y muerte celular, Curación y reparación, Alteraciones del crecimiento, diferenciación y maduración3Decks84Flashcards1Learner -
ANATOMIA PATOLOGICA 1
ANATOMIA PATOLOGICA 1
By: Sophia Bergamin
DEFINIZIONI GENERALI1Decks32Flashcards1Learner -
5º Período
5º Período
By: Luísa Bernardes
Anatomia Patológica, Clínica2Decks137Flashcards1Learner -
Anatomía Patológica 1er parcial
Anatomía Patológica 1er parcial
By: Vanessa Contreras
La célula, Respuesta celular, Inflamación...8Decks456Flashcards1Learner -
Anatomía Patológica
Anatomía Patológica
By: Patrícia Marins
Cáncer Gástrico, Patología De Glándulas Salivares, Patología Esofágica...5Decks77Flashcards1Learner -
anatomia patologica, mediastino
anatomia patologica, mediastino
By: Sofia Nughes
MEDIASTINITI CRONICHE SPECIFICHE, TUBERCOLOSI, MEDIASTINITE CRONICA SPEFICA...27Decks158Flashcards1Learner -
AnatoPato
AnatoPato
By: ana macho fernandez
Anatomía Patológica1Decks41Flashcards1Learner -
Histología Y Patología
Histología Y Patología
By: Emilio Guerrero
Técnicas De Histología Y Clasificación De Tejidos, Introducción A Ecología Y Microbiología, Introducción A La Anatomía Patológica...5Decks69Flashcards1Learner -
Laboratorio Anatomía Patológica
Laboratorio Anatomía Patológica
By: Rosa Quiroz
Cáncer Cervico Uterino, Cáncer De Mama2Decks21Flashcards1Learner -
Semiología

Semiología
By: Marta Silva Santos
UP01_Semiología, Anatomía patológica, Microbiologia...5Decks62Flashcards1Learner -
Anatomía Patológica 1, Banco 1er examen (Cátedras)
Anatomía Patológica 1, Banco 1er examen (Cátedras)
By: Antoine Lavoisier
Lesion Y Muerte Celular, Apoptosis, Inflamación3Decks81Flashcards1Learner -
Anatomia Patologica I
Anatomia Patologica I
By: Denisse Icaza
Trastornos del Sistema Inmune, Enfermedades del Sistema Inmunotario Cap.4 Edición29, Descripción de enfermedades 2do Parcial...4Decks70Flashcards1Learner -
Anatomia Patológica I
Anatomia Patológica I
By: Carlos Figueiredo
Fígado E Vias Biliares, Coração2Decks66Flashcards1Learner -
Anatomia Patológica
Anatomia Patológica
By: Lara Ribeiro
SAM, SM2Decks57Flashcards1Learner


